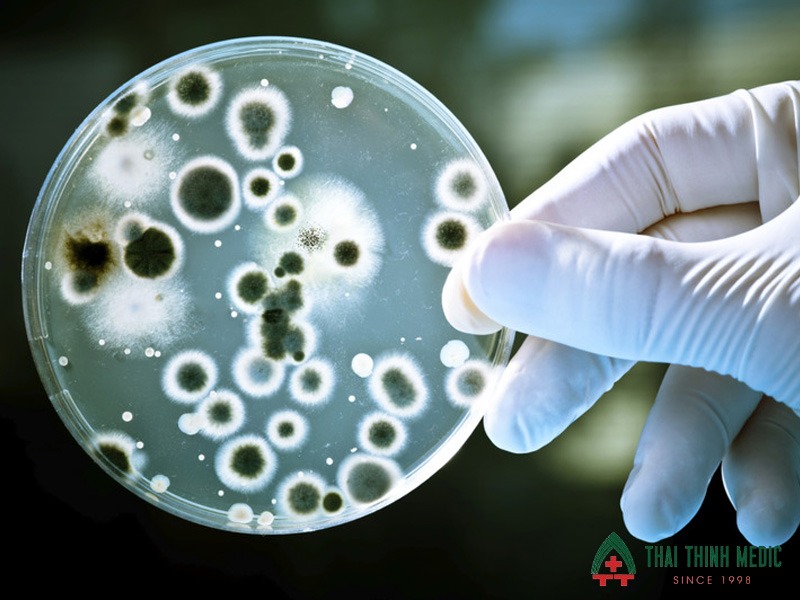
viem-phe-quan-co-lay-khong-do-virus

Viêm phế quản là một bệnh lý hô hấp phổ biến, nhưng vẫn có rất nhiều người thắc mắc viêm phế quản có lây không? Nguyên nhân gây bệnh có thể liên quan đến virus, vi khuẩn hoặc các yếu tố kích thích như khói bụi hay thời tiết. Theo Tổ chức Y tế Thế giới (WHO), các bệnh nhiễm trùng đường hô hấp cấp tính là một trong những nguyên nhân chính gây bệnh trên toàn cầu, đặc biệt là ở trẻ nhỏ và người cao tuổi. Điều này khiến nhiều người lo lắng về nguy cơ lây nhiễm khi tiếp xúc gần. Vậy viêm phế quản có lây không, lây qua đường nào và làm sao để phòng tránh hiệu quả? Nội dung trong bài viết dưới đây của Phòng khám 125 Thái Thịnh - Thai Thinh Medic sẽ giúp bạn hiểu rõ hơn.
Viêm phế quản có lây không?
Viêm phế quản có lây không? Bệnh có thể lây hoặc không lây, tùy thuộc vào nguyên nhân gây bệnh. Nếu viêm phế quản xuất phát từ virus hoặc vi khuẩn, bệnh hoàn toàn có khả năng lây từ người sang người qua đường hô hấp.
Ngược lại, nếu nguyên nhân đến từ các yếu tố như dị ứng, khói bụi, ô nhiễm không khí hoặc cơ địa nhạy cảm, thì viêm phế quản sẽ không lây. Chính vì vậy, để đánh giá nguy cơ lây nhiễm, cần xác định rõ nguyên nhân gây bệnh. Các trường hợp viêm phế quản cấp do virus là phổ biến nhất và cũng là nguyên nhân chính gây lây lan trong cộng đồng, đặc biệt vào thời điểm giao mùa hoặc khi thời tiết thay đổi.
- Do virus như cúm, virus hợp bào hô hấp (RSV) có thể gây viêm phế quản cấp và lây lan nhanh qua đường hô hấp khi người bệnh ho, hắt hơi hoặc nói chuyện gần.
- Do một số loại vi khuẩn có thể gây viêm phế quản và lây qua tiếp xúc gần, đặc biệt trong môi trường đông người hoặc kín như trường học, văn phòng.
- Lây qua giọt bắn đường hô hấp khi người bệnh ho, hắt hơi, các giọt bắn chứa mầm bệnh có thể phát tán trong không khí và xâm nhập vào cơ thể người khác.
- Tiếp xúc trực tiếp với dịch tiết, chạm vào tay, khăn giấy hoặc vật dụng có chứa dịch tiết của người bệnh rồi đưa lên mắt, mũi, miệng có thể làm tăng nguy cơ lây nhiễm.
- Môi trường kín, đông người trong không gian kém thông thoáng tạo điều kiện cho virus và vi khuẩn tồn tại lâu hơn, dễ lây lan hơn.
- Hệ miễn dịch suy yếu ở người có sức đề kháng kém (trẻ nhỏ, người già) dễ bị lây hơn khi tiếp xúc với nguồn bệnh.

Viêm phế quản có thể lây hoặc không lây
Những trường hợp viêm phế quản có thể lây nhiễm
Không phải tất cả các trường hợp viêm phế quản đều có khả năng lây. Lây nhiễm chủ yếu xảy ra khi bệnh có nguyên nhân từ tác nhân gây nhiễm trùng như virus hoặc vi khuẩn.
Viêm phế quản do virus
Viêm phế quản do virus là dạng phổ biến nhất và cũng là nguyên nhân chính gây lây nhiễm. Các loại virus như cúm, virus hợp bào hô hấp (RSV) hay rhinovirus có thể xâm nhập vào đường hô hấp, gây viêm niêm mạc phế quản và dẫn đến các triệu chứng như ho, sốt, đau họng. Những virus này dễ dàng lây lan từ người sang người thông qua các giọt bắn khi ho, hắt hơi hoặc nói chuyện ở khoảng cách gần.
Đặc biệt, trong giai đoạn đầu của bệnh khi triệu chứng còn nhẹ, người bệnh thường không ý thức được mình đang mang mầm bệnh và vẫn sinh hoạt bình thường, làm tăng nguy cơ lây lan cho người xung quanh. Môi trường đông người như trường học, văn phòng hoặc phương tiện công cộng là nơi virus dễ phát tán nhanh chóng.
- Lây qua giọt bắn khi ho, hắt hơi
- Nguy cơ lây cao trong 3–5 ngày đầu của bệnh
- Dễ bùng phát thành dịch trong cộng đồng
- Thường gặp vào thời điểm giao mùa
- Trẻ em và người già dễ bị lây nhiễm
Viêm phế quản do virus
Viêm phế quản do vi khuẩn
Mặc dù ít phổ biến hơn so với virus, viêm phế quản do vi khuẩn vẫn có khả năng lây lan trong một số trường hợp. Các vi khuẩn như Streptococcus pneumoniae hoặc Haemophilus influenzae có thể gây nhiễm trùng đường hô hấp, đặc biệt khi hệ miễn dịch suy yếu hoặc sau khi nhiễm virus trước đó.
Vi khuẩn có thể lây qua tiếp xúc trực tiếp với dịch tiết đường hô hấp hoặc qua các bề mặt bị nhiễm khuẩn. Tuy nhiên, khả năng lây của viêm phế quản do vi khuẩn thường thấp hơn so với virus và thường xảy ra trong môi trường có mật độ tiếp xúc cao hoặc vệ sinh kém.
Ngoài ra, không điều trị triệt để hoặc sử dụng kháng sinh không đúng cách có thể làm kéo dài thời gian mang mầm bệnh và tăng nguy cơ lây nhiễm.
- Lây qua tiếp xúc gần với người bệnh
- Có thể lây qua vật dụng nhiễm khuẩn
- Thường xảy ra khi miễn dịch suy giảm
- Nguy cơ tăng trong môi trường đông người
- Cần điều trị đúng để hạn chế lây lan

Viêm phế quản do vi khuẩn
Viêm phế quản cấp trong giai đoạn khởi phát
Giai đoạn đầu của viêm phế quản cấp là thời điểm bệnh dễ lây nhất, đặc biệt khi nguyên nhân là virus. Lúc này, số lượng mầm bệnh trong cơ thể cao và các triệu chứng như ho, hắt hơi, sổ mũi xuất hiện nhiều, tạo điều kiện thuận lợi phát tán mầm bệnh ra môi trường.
Nhiều người thường chủ quan trong giai đoạn này vì triệu chứng chưa nghiêm trọng, vẫn đi làm, đi học và tiếp xúc với người khác, vô tình trở thành nguồn lây nhiễm. Đây cũng là lý do khiến các bệnh hô hấp dễ lây lan nhanh trong cộng đồng.
Nhận biết sớm và có biện pháp phòng ngừa như đeo khẩu trang, hạn chế tiếp xúc sẽ giúp giảm nguy cơ lây lan đáng kể.
- Lây mạnh nhất trong giai đoạn đầu của bệnh
- Triệu chứng ho, hắt hơi làm phát tán mầm bệnh
- Người bệnh thường chưa ý thức được nguy cơ lây
- Dễ lây trong sinh hoạt hằng ngày
- Cần hạn chế tiếp xúc để bảo vệ người xung quanh

Viêm phế quản cấp trong giai đoạn khởi phát
Con đường lây nhiễm viêm phế quản
Viêm phế quản do virus hoặc vi khuẩn có thể lây lan qua nhiều con đường khác nhau, chủ yếu liên quan đến đường hô hấp và tiếp xúc gần. Hiểu rõ các đường lây giúp bạn chủ động phòng tránh và hạn chế nguy cơ nhiễm bệnh, đặc biệt trong môi trường đông người hoặc khi tiếp xúc với người đang mắc bệnh.
- Lây qua giọt bắn đường hô hấp: Đây là con đường lây phổ biến nhất. Khi người bệnh ho, hắt hơi hoặc nói chuyện, các giọt bắn chứa virus hoặc vi khuẩn sẽ phát tán vào không khí và có thể xâm nhập vào cơ thể người khác qua mũi, miệng.
- Lây qua tiếp xúc trực tiếp: Như bắt tay, chạm vào người bệnh hoặc tiếp xúc gần trong khoảng cách ngắn có thể làm tăng nguy cơ lây nhiễm, đặc biệt khi không có biện pháp bảo vệ như đeo khẩu trang.
- Lây qua bề mặt trung gian: Virus và vi khuẩn có thể tồn tại trên các bề mặt như tay nắm cửa, điện thoại, bàn ghế. Khi chạm vào những vật dụng này rồi đưa tay lên mắt, mũi, miệng, bạn có thể vô tình đưa mầm bệnh vào cơ thể.
- Lây trong môi trường kín, kém thông thoáng: Những không gian đông người, ít lưu thông không khí như văn phòng, lớp học, phương tiện công cộng là nơi mầm bệnh dễ tồn tại và lây lan nhanh hơn.
- Lây qua thói quen sinh hoạt: Dùng chung đồ cá nhân như cốc nước, khăn mặt hoặc không che miệng khi ho, hắt hơi cũng làm tăng nguy cơ phát tán mầm bệnh.
- Lây mạnh hơn khi sức đề kháng yếu: Trẻ nhỏ, người cao tuổi hoặc người có hệ miễn dịch suy giảm dễ bị nhiễm bệnh hơn khi tiếp xúc với nguồn lây.

Giọt bắn là con đường lây nhiễm viêm phế quản phổ biến
Thời điểm viêm phế quản dễ lây nhiễm
Khả năng lây của viêm phế quản không diễn ra liên tục mà thường tập trung vào một số giai đoạn nhất định, đặc biệt khi nguyên nhân là do virus hoặc vi khuẩn.
- Giai đoạn khởi phát từ 1- 3 ngày đầu là thời điểm mầm bệnh phát triển mạnh trong cơ thể, người bệnh bắt đầu xuất hiện các triệu chứng như ho, hắt hơi, sổ mũi,... làm tăng nguy cơ phát tán virus/vi khuẩn ra môi trường.
- Khi ho nhiều, hắt hơi liên tục tạo ra giọt bắn chứa mầm bệnh, dễ lây sang người xung quanh nếu không che chắn hoặc đeo khẩu trang.
- Khi có sốt và viêm cấp tính là dấu hiệu cơ thể đang phản ứng mạnh với tác nhân gây bệnh, đồng thời cũng là lúc khả năng lây nhiễm cao hơn.
- Trong môi trường đông người, kín như văn phòng, lớp học, phương tiện công cộng – nơi mầm bệnh dễ lan truyền nhanh chóng.
- Khi chưa được điều trị hoặc điều trị chưa đúng cách khiến người bệnh vẫn mang nhiều mầm bệnh và có thể lây sang người khác trong thời gian dài hơn.

Giai đoạn khởi phát dễ lây nhiễm viêm phế quản
Đối tượng dễ bị lây nhiễm viêm phế quản
Không phải ai tiếp xúc với người bệnh cũng bị lây viêm phế quản, tuy nhiên một số nhóm đối tượng có nguy cơ cao hơn do hệ miễn dịch yếu hoặc thường xuyên tiếp xúc với nguồn bệnh, cần chủ động phòng ngừa.
- Trẻ nhỏ, đặc biệt dưới 5 tuổi có hệ miễn dịch của trẻ chưa hoàn thiện, đường hô hấp nhạy cảm nên dễ bị virus, vi khuẩn tấn công khi tiếp xúc với nguồn lây.
- Người cao tuổi sức đề kháng suy giảm theo tuổi tác khiến cơ thể khó chống lại tác nhân gây bệnh, dễ nhiễm và bệnh cũng có xu hướng nặng hơn.
- Người có hệ miễn dịch suy yếu, bao gồm người mắc bệnh mạn tính (tiểu đường, tim mạch), người đang điều trị bằng thuốc ức chế miễn dịch hoặc sau phẫu thuật.
- Người có bệnh lý hô hấp nền như hen phế quản, hen suyễn, viêm phổi mạn tính, viêm mũi dị ứng… khiến đường thở nhạy cảm hơn với tác nhân gây bệnh.
- Người thường xuyên tiếp xúc môi trường đông người như nhân viên văn phòng, học sinh, người làm việc trong không gian kín có nguy cơ cao do dễ tiếp xúc với giọt bắn chứa mầm bệnh.
- Người hút thuốc lá hoặc sống trong môi trường ô nhiễm do khói thuốc và bụi mịn làm tổn thương niêm mạc đường hô hấp, tạo điều kiện cho vi khuẩn, virus xâm nhập.
- Người chăm sóc trực tiếp bệnh nhân nếu không có biện pháp bảo vệ như đeo khẩu trang, rửa tay thường xuyên, nguy cơ lây nhiễm sẽ cao hơn.

Người có sức đề kháng kém, trẻ nhỏ, người cao tuổi dễ bị lây nhiễm viêm phế quản
Cách phòng tránh lây viêm phế quản hiệu quả
Viêm phế quản do virus hoặc vi khuẩn có thể lây lan nhanh nếu không có biện pháp phòng ngừa phù hợp. Đặc biệt trong môi trường đông người hoặc khi có người mắc bệnh trong gia đình, vì thế chủ động bảo vệ bản thân và người xung quanh rất quan trọng.
- Đeo khẩu trang khi tiếp xúc gần giúp ngăn chặn giọt bắn chứa virus, vi khuẩn từ người bệnh phát tán ra môi trường và xâm nhập vào cơ thể.
- Rửa tay thường xuyên bằng xà phòng, đặc biệt sau khi ho, hắt hơi, tiếp xúc với người bệnh hoặc chạm vào các bề mặt công cộng.
- Tránh đưa tay lên mắt, mũi, miệng vì đây là con đường dễ đưa mầm bệnh từ tay vào cơ thể.
- Hạn chế tiếp xúc gần với người đang mắc bệnh, giữ khoảng cách an toàn, tránh bắt tay hoặc dùng chung đồ cá nhân.
- Không dùng chung vật dụng cá nhân như cốc nước, khăn mặt, bàn chải đánh răng để tránh lây nhiễm gián tiếp.
- Che miệng khi ho, hắt hơi nên sử dụng khăn giấy hoặc khuỷu tay để hạn chế phát tán giọt bắn.
- Giữ môi trường sống thông thoáng, mở cửa, lưu thông không khí để giảm концентраtion mầm bệnh trong không gian kín.
- Tăng cường sức đề kháng, ăn uống đầy đủ dinh dưỡng, ngủ đủ giấc và tập thể dục giúp cơ thể chống lại tác nhân gây bệnh tốt hơn.
- Tiêm phòng các bệnh hô hấp như vaccine cúm giúp giảm nguy cơ mắc các bệnh gây viêm phế quản.

Phòng ngừa viêm phế quản
Câu hỏi thường gặp về viêm phế quản
Viêm phế quản có lây qua ăn uống không?
Viêm phế quản không lây trực tiếp qua đường ăn uống. Tuy nhiên, nếu dùng chung bát đũa, cốc nước với người bệnh, bạn vẫn có nguy cơ tiếp xúc với virus hoặc vi khuẩn qua nước bọt.
Viêm phế quản có cần cách ly không?
Không cần cách ly nghiêm ngặt như một số bệnh truyền nhiễm nguy hiểm, nhưng người bệnh nên hạn chế tiếp xúc gần, đeo khẩu trang và giữ khoảng cách để tránh lây lan cho người khác.
Viêm phế quản lây trong bao lâu?
Thời gian lây thường cao nhất trong 3–5 ngày đầu khi triệu chứng khởi phát. Tuy nhiên, người bệnh vẫn có thể lây trong suốt thời gian còn ho, hắt hơi.

Thời gian lây cao nhất trong 3- 5 ngày
Tiếp xúc với người bị viêm phế quản có chắc chắn bị lây không?
Không. Nguy cơ lây còn phụ thuộc vào nguyên nhân gây bệnh và sức đề kháng của mỗi người. Nếu hệ miễn dịch tốt và có biện pháp phòng ngừa, khả năng bị lây sẽ thấp hơn.
Trẻ em có dễ bị lây viêm phế quản không?
Có. Trẻ nhỏ là nhóm có nguy cơ cao do hệ miễn dịch chưa hoàn thiện và thường xuyên tiếp xúc gần trong môi trường như trường học, nhà trẻ.
Viêm phế quản mạn tính có lây không?
Không. Viêm phế quản mạn tính thường liên quan đến yếu tố như hút thuốc, ô nhiễm môi trường hoặc bệnh nền, không phải do tác nhân lây nhiễm.
Với những thông tin được chia sẻ từ bài viết mong rằng đã giúp bạn trả lời được câu hỏi viêm phế quản có lây không. Viêm phế quản có thể lây nhiễm hoặc không, tùy thuộc vào nguyên nhân gây bệnh, trong đó, các trường hợp do virus, vi khuẩn có nguy cơ lây cao hơn. Hiểu rõ cơ chế lây, thời điểm dễ lây và cách phòng tránh sẽ giúp bạn chủ động bảo vệ sức khỏe cho bản thân và gia đình. Nếu xuất hiện các triệu chứng như ho kéo dài, sốt hoặc khó thở, bạn nên thăm khám sớm để được chẩn đoán chính xác, hãy liên hệ ngay Phòng khám 125 Thái Thịnh - Thai Thinh Medic ngay nhé!




